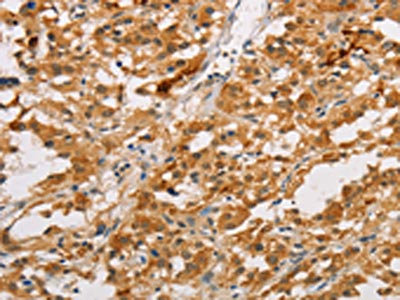

ARMCX3 Antibody
-
中文名稱:ARMCX3兔多克隆抗體
-
貨號:CSB-PA916723
-
規(guī)格:¥1100
-
圖片:
-
The image on the left is immunohistochemistry of paraffin-embedded Human cervical cancer tissue using CSB-PA916723(ARMCX3 Antibody) at dilution 1/40, on the right is treated with fusion protein. (Original magnification: ×200)
-
The image on the left is immunohistochemistry of paraffin-embedded Human thyroid cancer tissue using CSB-PA916723(ARMCX3 Antibody) at dilution 1/40, on the right is treated with fusion protein. (Original magnification: ×200)
-
-
其他:
產品詳情
-
Uniprot No.:
-
基因名:ARMCX3
-
別名:ARMCX3 antibody; ALEX3 antibody; BM-017 antibody; UNQ2517/PRO6007Armadillo repeat-containing X-linked protein 3 antibody; ARM protein lost in epithelial cancers on chromosome X 3 antibody; Protein ALEX3 antibody
-
宿主:Rabbit
-
反應種屬:Human,Mouse,Rat
-
免疫原:Fusion protein of Human ARMCX3
-
免疫原種屬:Homo sapiens (Human)
-
標記方式:Non-conjugated
-
抗體亞型:IgG
-
純化方式:Antigen affinity purification
-
濃度:It differs from different batches. Please contact us to confirm it.
-
保存緩沖液:-20°C, pH7.4 PBS, 0.05% NaN3, 40% Glycerol
-
產品提供形式:Liquid
-
應用范圍:ELISA,IHC
-
推薦稀釋比:
Application Recommended Dilution ELISA 1:1000-1:5000 IHC 1:50-1:200 -
Protocols:
-
儲存條件:Upon receipt, store at -20°C or -80°C. Avoid repeated freeze.
-
貨期:Basically, we can dispatch the products out in 1-3 working days after receiving your orders. Delivery time maybe differs from different purchasing way or location, please kindly consult your local distributors for specific delivery time.
-
用途:For Research Use Only. Not for use in diagnostic or therapeutic procedures.
相關產品
靶點詳情
-
功能:Regulates mitochondrial aggregation and transport in axons in living neurons. May link mitochondria to the TRAK2-kinesin motor complex via its interaction with Miro and TRAK2. Mitochondrial distribution and dynamics is regulated through ARMCX3 protein degradation, which is promoted by PCK and negatively regulated by WNT1. Enhances the SOX10-mediated transactivation of the neuronal acetylcholine receptor subunit alpha-3 and beta-4 subunit gene promoters.
-
基因功能參考文獻:
- reduction of Alex3 correlates with the development of non-small cell lung cancer and predicts adverse clinical outcome of non-small cell lung cancer patients. The effect of Alex3 on inhibiting invasion and migration may attribute to upregulation of E-cadherin expression through AKT-Slug pathway inactivation. PMID: 28705116
- The Wnt pathway regulates mitochondrial distribution and dynamics through Alex3 protein degradation. PMID: 23844091
-
亞細胞定位:Mitochondrion outer membrane; Single-pass membrane protein. Cytoplasm. Nucleus.
-
蛋白家族:Eutherian X-chromosome-specific Armcx family
-
數(shù)據(jù)庫鏈接:
Most popular with customers
-
-
Phospho-YAP1 (S127) Recombinant Monoclonal Antibody
Applications: ELISA, WB, IHC
Species Reactivity: Human
-
-
-
-
-
-